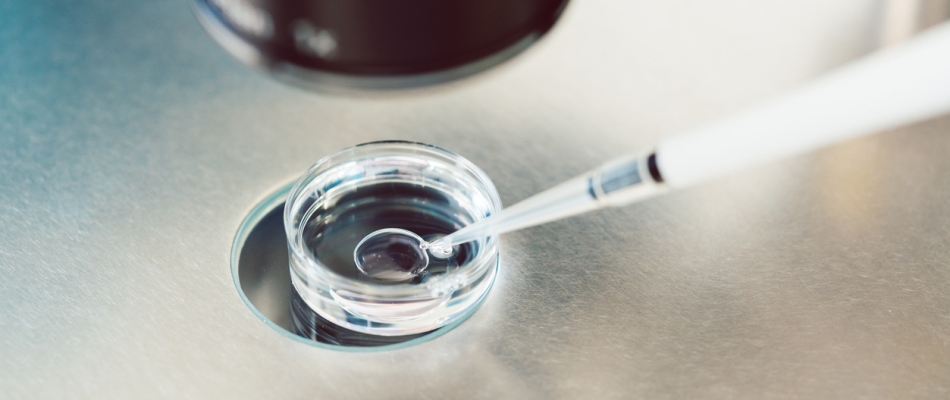
Le diagnostic préimplantatoire fait toujours débat - Minizap Nord-Isère

Le diagnostic préimplantatoire fait toujours débat
Revendiquée pour notamment réduire le nombre de tentatives – et d'échecs – de fécondation in vitro des personnes en parcours d'assistance médicale à la procréation, l'autorisation du diagnostic préimplantatoire des aneuploïdies se heurte toujours à une vive opposition.
Mis sur le devant de la scène par la secrétaire nationale des Écologistes, Marine Tondelier, lors de l'annonce de sa grossesse en mars 2026 et son parcours en assistance médicale à la procréation (AMP), le diagnostic préimplantatoire des aneuploïdies (DPI-A) continue de diviser, entre partisans souhaitant le voir inscrit dans la loi, et détracteurs, opposés à ce procédé. Cette technique, qui permet la détection d'anomalies chromosomiques des embryons avant leur transfert dans le cadre d'une AMP, est en effet toujours interdite dans l'Hexagone, bien qu'elle soit autorisée dans plusieurs États européens, comme l'Espagne ou la Belgique.
Alors que « 3,3 millions de personnes en France rencontrent des difficultés pour concevoir un enfant » et qu'une crise de natalité historique touche le pays, les solutions médicales actuellement proposées « ne suivent pas l'évolution des besoins ni des connaissances scientifiques », alerte le collectif BAMP, spécialisé dans l'accompagnement des personnes confrontées à l'infertilité. D'autres, au contraire, s'inquiètent de la création d'un droit à trier ses embryons…
Un diagnostic strictement encadré
Lors d'une fécondation in vitro (FIV) dans un parcours d'AMP, des gamètes féminines et masculines sont fécondés en laboratoire. Il en résulte alors des embryons qui sont par la suite implantés dans l'utérus de la femme. Actuellement en France, un diagnostic préimplantatoire (DPI) n'est autorisé qu'à titre exceptionnel et sous conditions pour détecter certaines maladies génétiques graves et incurables. Le DPI-A, pour repérer des aneuploïdies – des anomalies chromosomiques comme une trisomie ou une monosomie –, est quant à lui interdit, quand bien même elles constituent une cause courante d'échec d'implantation.
Une question de viabilité
Si un embryon viable peut être implanté du premier coup et arriver à terme, il se peut néanmoins que des patientes subissent un ou plusieurs transferts d'embryons avec anomalies, aboutissant à des fausses couches sur répétition. La fréquence d'aneuploïdie et les risques d'échecs augmentent d'ailleurs avec l'âge de la femme. La détresse est tant physique que mentale pour les patientes, qui, en plus de ne pas voir leur désir de grossesse se réaliser, subissent généralement de lourds et éprouvants traitements, dont des stimulations hormonales. Outre ces souffrances, le parcours d'AMP s'en voit rallongé, parfois étendu sur plusieurs années au lieu de quelques mois.
Comme le résume le collectif BAMP, le DPI-A permet ainsi d'éviter « des échecs prévisibles, des fausses couches douloureuses, des traitements hormonaux lourds, et des dépenses publiques inutiles ». Des réussites plus rapides contribueraient également à libérer de la place dans des centres de PMA (ancienne appellation de l'AMP) actuellement saturés. Enfin, des diagnostics qui ne montreraient que des embryons avec des anomalies permettraient de guider les patients vers d'autres solutions, comme l'adoption, sans perdre de temps.
Un vif débat
En 2021, lors de la révision de la loi sur la bioéthique, le DPI-A avait été rejeté par les parlementaires. Pour certains détracteurs du diagnostic préimplantatoire, souvent conservateurs ou « pro-vie », la technique est considérée comme « eugéniste », allant à l'encontre des personnes porteuses de trisomies et créant un droit à trier ou des attentes d'un bébé sans défaut. À l'inverse, le Comité consultatif national d'éthique a estimé, dans un avis de 2021, que ce terme était inapproprié puisque l'eugénisme se définit comme la volonté d'améliorer la race humaine. Or, selon cet organisme, le DPI-A vise à sélectionner des embryons « plus viables » et non « plus désirables ». Il rappelle d'ailleurs que le recours à une interruption médicale de grossesse (IMG) reste autorisé en cas de détection de trisomie 21 pendant la grossesse… dénotant un paradoxe de l'interdire à un stade préimplantatoire. La prochaine révision de la loi, sûrement après l'élection présidentielle de 2027, pourrait remettre le sujet sur la table.
Un congé pathologique plus long

Maladies mentales, des gènes communs

Une appli pour bien se brosser les dents